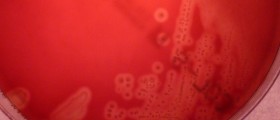
Group B Strep in Pregnancy

Study: egg donation doesn't cause infertility
Have you ever thought of becoming an egg donor to help someone else have a baby, and perhaps to make some money? Donating eggs is a complicated process that is...

Back massage during labor
Many pregnant women dread the moment they go into labor and have contractions during their whole pregnancy, especially if they are first time mothers. Most women are most afraid of...

Listeria infection in pregnancy
During pregnancy, some foods should be avoided. Raw meat, too much mercury-filled fish, and mayonnaise with raw eggs are some examples. Dairy products that are not pasteurized can cause trouble...

Modified bed rest during pregnancy: what and why?
There are many different reasons a woman can be recommended to go on bed rest during pregnancy carrying twins or having a history of premature labor are just two examples...

Running, jogging and pregnancy
Staying physically fit and active during pregnancy is hugely beneficial. But some types of prenatal exercise are better than others. What is the deal with running and jogging while you...

Maternal obesity and diabetes lead to autism?
Obesity and diabetes type 2 are bad news, especially during pregnancy. But according to a new study, a mom's obesity or diabetes while pregnant may also contribute to a child's...

Does a large for dates baby mean a cesarean, especially if mom is overweight?
Babies who are large for gestational length, and have fetal macrosomnia, have a higher risk of being injured during a vaginal birth especially due to shoulder dystocia. That is, if...

Nosebleeds during pregnancy
Are you suffering from nosebleeds during pregnancy? This can be quite worrying, not to mention irritating and socially embarrassing. But are nosebleeds during pregnancy normal? Let's take a look at...
Group B Strep in Pregnancy
Group B Strep, also known as GBS, is an infection that can cause serious trouble for newborns if it is not addressed during labor and birth. What does GBS mean...

Study: Women spend longer in labor than 50 years back
Many doctors today put laboring women on the clock, "threatening" to give them a cesarean section if they don't give birth within 24 hours of starting labor. But they may...

